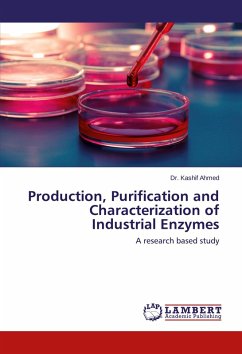
Production, Purification and Characterization of Industrial Enzymes

Transition elements are the main component of the active centers found in many proteins. The active centers of these proteins consists of the transition element atom linked to nitrogen atoms or oxygen or sulfur arising from some amino acids The active centers formed naturally in the biological processes to do a very distinctive job under physiological conditions for each protein, such as converting nitrogen to ammonia or fixing atmospheric nitrogen in order to be available to the plant. It was therefore necessary to find several attempts to identify the composition of the active centers and to shed light on the mechanism of the interaction of these proteins. From this stand point, the study was aimed at new attempts to explain the mechanism functioning of some of the interactions of enzymes and proteins through the design and preparation of some complexes of transition element models simulate the structure (structural model) and functional (functional models) of the nitroganases enzymes.
Bitte wählen Sie Ihr Anliegen aus.
Rechnungen
Retourenschein anfordern
Bestellstatus
Storno
![Iron (II) and Ruthenium (II) Sulfur complexes modelling [MS] enzymes - Shaban, Shaban Iron (II) and Ruthenium (II) Sulfur complexes modelling [MS] enzymes - Shaban, Shaban](https://bilder.buecher.de/produkte/35/35517/35517145n.jpg)